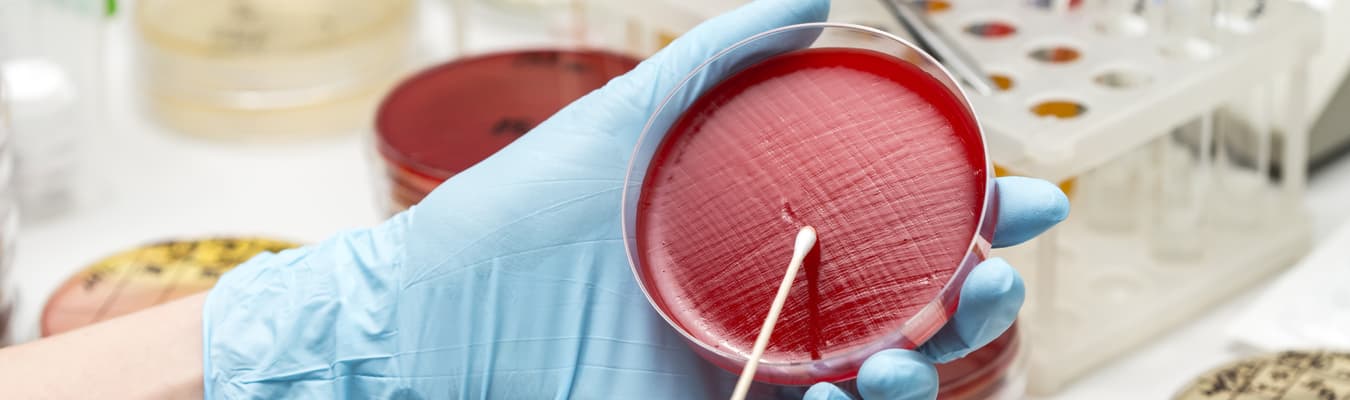

Validación de Métodos Microbiológicos (Límites Microbianos, Esterilidad y Endotóxina)
| Inicia: | 14 de Marzo | 2026 |
|---|---|
| Termina: | 21 de Marzo | 2026 |
| Tipo: | Curso |
| Sede: | ONLINE |
| Ponente: | QBP. Francisco Huerta Sánchez |
| Organizador: | CONSUFARMA |
| Horario: | 8:00 – 16:00 |

OBJETIVOS
- Conocerá a detalle el proceso de implementación de validación de métodos microbiológicos, de acuerdo a la regulación vigente.
- Conocerá los requerimientos para documentar apropiadamente las validaciones microbiológicas
TEMARIO
- Conceptos de Validación.
- Generalidades
- Definiciones relacionadas
- Objetivo de la Validación
- Situación regulatoria nacional e internacional (NOM 059, FDA).
- Validación microbiológica de la prueba de esterilidad
- ¿Qué es la prueba de esterilidad?
- Generalidades
- Tipos de métodos
- Medios de cultivo
- Incubación
- Interpretación de resultados
- Requisitos para ejecutar prueba de esterilidad
- Instalaciones
- Equipos
- Personal
- Insumos
- Consideraciones durante la ejecución de la prueba
- Validación de la prueba de esterilidad
- Aptitud del método
- Prueba de bacteriostasis y fungistasis
- Selección de la solución de enjuague
- Selección del agente inactivante.
- Microorganismos de prueba
- Condiciones de incubación
- Controles
- Interpretación de resultados
- Criterios de aceptación
- ¿Qué es la prueba de esterilidad?
- Validación prueba de endotoxina
- ¿Qué es la prueba de endotoxina?
- Generalidades
- Tipos de métodos
- Método Gel-Clot
- Turbidimétrico
- Interpretación de resultados
- Requisitos para ejecutar prueba de endotoxina
- Instalaciones
- Equipos
- Personal
- Insumos
- Consideraciones durante la ejecución de la prueba
- ¿Qué es la prueba de endotoxina?
- Validación microbiológica de LÍmites Microbianos
- ¿Qué es la prueba de Límites Microbianos?
- Generalidades
- Tipos de métodos
- Métodos de recuento en placa
- Método del Número Más Probable.
- Interpretación de resultados
- Requisitos para ejecutar prueba de límites microbianos.
- Instalaciones
- Equipos
- Personal
- Insumos
- Consideraciones durante la ejecución de la prueba
- Validación de la prueba de Límite microbianos.
- Aptitud del método de recuento en presencia de producto.
- Aptitud del método de prueba de microorganismos específicos
- Neutralización/Eliminación de la actividad antimicrobiana.
- Microorganismos de prueba
- Recuperación de microorganismos
- Condiciones de incubación
- Controles
- Interpretación de resultados
- Criterios de aceptación
- Validación de la prueba de endotoxina
- Prueba de inhibición y potencialización
- Selección de soluciones de prueba
- Selección de sensibilidad de reactivo LAL
- Prueba de inhibición
- Prueba de potencialización
- Condiciones de incubación
- Controles
- Interpretación de resultados
- Criterios de aceptación
- Condiciones de incubación
- Controles
- Interpretación de resultados
- Criterios de aceptación
- Aptitud del método de prueba de microorganismos específicos
- ¿Qué es la prueba de Límites Microbianos?
INSTRUCTOR
QBP Francisco Huerta Sánchez
Más de 21 años de experiencia acumulada en la industria farmacéutica nacional y transnacional, ha trabajado en posiciones gerenciales en el área de Microbiología y como Auditor en operaciones de calidad; cuenta con experiencia en aseguramiento de la calidad, Buenas Prácticas de Fabricación del laboratorio de Microbiología, validación de procesos de fabricación y limpieza de sistemas críticos, análisis microbiológico, transferencia de metodología microbiana, entre otras.
INFORMACIÓN GENERAL
Recibirás por correo un link para acceder a tu curso en TIEMPO REAL.
Precio a Empresas (por participante): ver ►Más información
Pago personal: Consulta nuestro precio especial y opción a meses sin interéses, ver ►Más información
¿QUÉ INCLUYEN NUESTROS CURSOS?

WhatsApp: +(52) 56 4000 9095
Correo electrónico: pedro.valadez@consufarma.com
Página web: www.consufarma.com
Información de la Sede
ONLINE
Conéctate desde cualquier lugar.
PC - Móviles - Tablets, Windows, MacOS, Android, ONLINE.